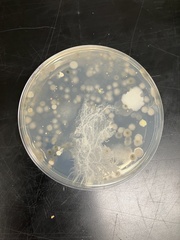
Bacillus mycoides

Bacillus mycoides: taxon details and analytics
- Domain
- Kingdom
- Bacteria
- Phylum
- Firmicutes
- Class
- Bacilli
- Order
- Bacillales
- Family
- Bacillaceae
- Genus
- Bacillus
- Species
- Bacillus mycoides
- Scientific Name
- Bacillus mycoides
Summary description from Wikipedia:
Bacillus mycoides
Bacillus mycoides is a bacterium of the genus Bacillus. Like other Bacillus species, B. mycoides is Gram positive, rod-shaped, and forms spores. B. mycoides is distinguished from other Bacillus species by its unusual growth on agar plates, where it forms expansive hairy colonies with characteristic swirls.
...Parent Taxon
Sibling Taxa
- Bacillus amyloliquefaciens
- Bacillus anthracis
- Bacillus cereus
- Bacillus circulans
- Bacillus coahuilensis
- Bacillus djibelorensis
- Bacillus fumarioli
- Bacillus fusiformis
- Bacillus granadensis
- Bacillus hwajinpoensis
- Bacillus insolitus
- Bacillus licheniformis
- Bacillus longiquaesitum
- Bacillus megaterium
- Bacillus muralis
- Bacillus mycoides
- Bacillus niameyensis
- Bacillus odysseyi
- Bacillus ohbensis
- Bacillus olivae
- Bacillus paralicheniformis
- Bacillus pseudomegaterium
- Bacillus psychrodurans
- Bacillus psychrotolerans
- Bacillus pumilus
- Bacillus simplex
- Bacillus sphaericus
- Bacillus subtilis
- Bacillus thermoamyloliquefaciens
- Bacillus thuringiensis